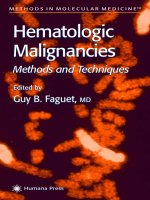
hematologic malignancies, methods and techniques

advanced organic synthesis, methods and techniques - r. monson (1974) ww
Bạn đang xem bản rút gọn của tài liệu. Xem và tải ngay bản đầy đủ của tài liệu tại đây (9.03 MB, 209 trang )
Advanced
Organic Synthesis
METHODS
AND
TECHNIQUES
RICHARD
S.
MONSON
DEPARTMENT
OF
CHEMISTRY
CALIFORNIA
STATE
COLLEGE,
HAYWARD
HAYWARD,
CALIFORNIA
ACADEMIC PRESS
New
York
and
London
COPYRIGHT
©
1971,
BY
ACADEMIC
PRESS,
INC.
ALL
RIGHTS RESERVED
NO
PART
OF
THIS BOOK
MAY BE
REPRODUCED
IN ANY
FORN
BY
PHOTOSTAT, MICROFILM, RETRIEVAL SYSTEM,
OR ANY
OTHER
MEANS, WITHOUT WRITTEN PERMISSION FROM
THE
PUBLISHERS.
ACADEMIC PRESS, INC.
Ill
Fifth
Avenue,
New
York,
New
York 10003
United
Kingdom Edition published
by
ACADEMIC PRESS, INC. (LONDON) LTD.
Berkeley
Square House, London
WlX
6BA
LIBRARY
OF
CONGRESS CATALOG CARD NUMBER:
75-165531
PRINTED
IN THE
UNITED
STATES
OF
AMERICA
Contents
Preface
xi
I.
FUNCTIONAL GROUP MODIFICATIONS
1.
Chemical
Oxidations
I.
Chromium Trioxide Oxidation
3
II.
Periodate-Permanganate
Cleavage
of
Olefins
5
III.
Free
Radical Oxidation
of an
Allylic Position
7
IV.
Epoxidation
of
Olefins
8
V.
Baeyer-Villiger Oxidation
of
Ketones
9
VI.
Lead Tetraacetate Oxidation
of
Cycloalkanols
11
VII. Photolytic Conversion
of
Cyclohexane
to
Cyclohexanone
Oxime
11
VIII. Oxidation
of
Ethers
to
Esters
12
IX.
Partial Oxidation
of an
Aliphatic Side Chain
13
X.
Bisdecarboxylation
with Lead
Tetraacetate
14
XI.
Oxidation with Selenium Dioxide
15
References
16
2.
Hydride
and
Related
Reductions
I.
Reduction
by
Lithium Aluminum Hydride
18
II.
Mixed Hydride Reduction
20
III. Reduction with Iridium-Containing Catalysts
22
IV.
Reduction
of
Conjugated Alkenes with Chromium
(H)
Sulfate
23
References
24
3.
Dissolving
Metal
Reductions
I.
Reduction
by
Lithium-Amine
25
II.
Reduction
by
Lithium-Ethylenediamine
26
III. Reduction
of
a,/MJnsaturated
Ketones
by
Lithium-Ammonia
27
IV.
Reduction
of
a,/9-Unsaturated
Ketones
in
Hexamethylphosphoric
Triamide
28
V.
Reduction
of an
a,/?-Unsaturated
y-Diketone
with
Zinc
29
References
30
VI
CONTENTS
4.
Hydroboration
I.
Hydroboration
of
Olefins
as a
Route
to
Alcohols
32
II.
Selective Hydroborations Using Bis(3-methyl-2-butyl)borane (BMB)
35
III.
Purification
of
a
Mixture
of
J
9
-
10
-
and
J
1(9)
-Octalins
37
References
38
5.
Catalytic
Hydrogenation
I.
Hydrogenation over Platinum Catalyst
39
II.
Low-Pressure Hydrogenation
of
Phenols over Rhodium Catalysts
40
III.
c/j-4-Hydroxycyclohexanecarboxylic
Acid from
/?-Hydroxybenzoic
Acid
41
IV.
3-Isoquinuclidone
from/7-Aminobenzoic
Acid
42
V.
Homogeneous
Catalytic Hydrogenation
43
References
44
6.
The
Introduction
of
Halogen
I.
Halides from Alcohols
by
Triphenylphosphine—Carbon
Tetrahalide
45
II.
Halides from Alcohols
and
Phenols
by
Triphenylphosphine Dihalide
46
III. Allylic
and
Benzylic Bromination with
W-Bromosuccinimide
48
IV.
a-Bromination
of
Ketones
and
Dehydrobromination
49
V.
Stereospecific
Synthesis
of
/ra/w-4-Halocyclohexanols
51
References
52
7.
Miscellaneous
Elimination,
Substitution,
and
Addition Reactions
I.
Methylenecyclohexane
by
Pyrolysis
of an
Amine
Oxide
54
II. The
Wolff-Kishner
Reduction
55
III. Dehydration
of
2-Decalol
56
IV.
Boron
Trifluoride
Catalyzed Hydrolysis
of
Nitriles
56
V.
Bridged
Sulfides
by
Addition
of
Sulfur
Dichloride
to
Dienes
57
VI.
Methylation
by
Diazomethane
58
VII.
Oxymercuration:
A
Convenient Route
to
Markovnikov Hydration
of
Olefins
.
60
VIII.
Esterification
of
Tertiary Alcohols
62
IX.
Ketalization
63
X.
Half-EsterificationofaDiol
64
XI.
Substitution
on
Ferrocene
65
XII.
Demethylation
of
Aryl
Methyl
Ethers
by
Boron Tribromide
66
References
67
CONTENTS
VlI
II.
SKELETAL
MODIFICATIONS
8. The
Diels-Alder
Reaction
I.
3,6-Diphenyl-4,5-cyclohexenedicarboxylic
Anhydride
71
II.
Reactions with Butadiene
72
III. Catalysis
by
Aluminum Chloride
74
IV.
Generation
of
Dienes from
Diones
75
V.
Reactions
with
Cyclopentadiene
77
References
79
9.
Enamines
as
Intermediates
I.
Preparation
of the
Morpholine Enamine
of
Cyclohexanone
80
II.
Acylation
of
Enamines
81
III. Enamines
as
Michael Addition Reagents
82
IV.
Reactions
of
Enamines with
j3-Propiolactone
83
V.
Reactions
of
Enamines with Acrolein
84
References
86
10.
Enolate Ions
as
Intermediates
I.
Ketones
as
Enolates:
Car
bethoxylation
of
Cyclic Ketones
87
II.
Esters
as
Enolates:
1,4-Cyclohexanedione
and
Meerwein's
Ester
90
III.
Methylsulfinyl
Carbanion
as a
Route
to
Methyl Ketones
92
IV.
Cyclization with Diethyl Malonate
96
V.
Carboxylations with Magnesium Methyl Carbonate (MMC)
97
VI.
Alkylation
of
j3-Ketoesters
99
VII.
The
Robinson Annelation Reaction
101
References
103
1
1
.
The
Wittig
Reaction
I.
Benzyl-Containing Ylides
104
II.
Alkyl
Ylides Requiring
«-Butyl
Lithium
105
III.
Methylsulfinyl
Carbanion
in the
Generation
of
Ylides
106
IV.
The
Wittig Reaction Catalyzed
by
Ethylene
Oxide
107
V.
Cyclopropylidene Derivatives
via the
Wittig Reaction
108
References
110
1
2
.
Reactions
of
Trialkylbor
anes
I.
Trialkylcarbinols
from
Trialkylboranes
and
Carbon Monoxide
Ill
II.
Dialkylketones
from
Trialkylboranes
and
Carbon
Monoxide-
Water
112
III.
The
Reaction
of
Trialkylboranes with Methyl
Vinyl
Ketone
and
Acrolein
114
IV.
The
Reaction
of
Trialkylboranes with Ethyl Bromoacetate
115
References
115
Viil
CONTENTS
13.
Carbenes
as
Intermediates
I.
Carbene
Addition
by the
Zinc-Copper
Couple
116
II.
Dibromocarbenes
117
III.
Dihalocarbenes
from Phenyl(trihalomethyl)mercury Compounds
119
References
120
14.
Ethynylation
I.
Generation
of
Sodium Acetylide
in
Liquid Ammonia
121
II. The
Generation
of
Sodium Acetylide
in
Tetrahydrofuran
123
III.
The
Generation
of
Sodium Acetylide
via
Dimsylsodium
124
References
125
15.
Structural
Isomerizations
I.
Acid Catalyzed Rearrangement
of
Saturated Hydrocarbons
126
II.
Photolytic Ring Contraction
127
III. Isomerization
of
1-Ethynylcylohexanol:
Three Methods
129
IV.
Photolytic Isomerization
of
1,5-Cyclooctadiene
130
V.
Oxidative Rearrangement
of
/3-Diketones
130
VI.
Base Catalyzed Rearrangement
of
4-Benzoyloxycyclohexanone
131
VII. Allenes from
1,1-Dihalocyclopropanes
by
Methyllithium
132
References
133
16.
Elimination,
Substitution,
and
Addition Reactions Resulting
in
Carbon-Carbon
Bond Formation
I.
Carboxylation
of
Carbonium Ions
134
II.
Paracyclophane
via a
1,6-Hofmann
Elimination
136
III. Diphenylcyclopropenone
from
Commercial Dibenzyl Ketone
137
IV.
Phenylcyclopropane from Cinnamaldehyde
139
V.
Conversion
of
Alkyl
Chlorides
to
Nitriles
in
DMSO
140
VI.
Photolytic Addition
of
Formamide
to
Olefins
141
VII.
Intermolecular
Dehydrohalogenation
142
VIII. Ring Enlargement with
Diazomethane
143
IX.
Conjugate
Addition
of
Grignard Reagents
144
X.
Dimethyloxosulfonium
Methylide
in
Methylene
Insertions
145
Xl.
Acylation
of a
Cycloalkane:
Remote Functionalization
147
XII.
The
Modified
Hunsdiecker Reaction
149
References
150
CONTENTS
IX
17.
Miscellaneous
Preparations
I.
Derivatives
of
Adamantane
151
II.
Percarboxylic Acids
153
III. Diazomethane
155
IV.
Trichloroisocyanuric
Acid
156
References
157
Appendix
1.
Examples
of
Multistep
Syntheses
158
Appendix
2.
Sources
of
Organic Reagents
161
Appendix
3.
Introduction
to the
Techniques
of
Synthesis
I. The
Reaction
166
II.
TheWorkup
175
III.
Purification
of the
Product
178
References
188
Subject
Index
189
Preface
The
developments
in
organic synthesis
in
recent years have been
as
dramatic
as any
that
have occurred
in
laboratory
sciences.
One
need only mention
a
few
terms
to
under-
stand
that
chemical systems
that
did not
exist twenty years
ago
have become
as
much
a
part
of the
repertoire
of the
synthetic organic chemist
as
borosilicate glassware.
The
list
of
such terms would include
the
Wittig reaction, enamines, carbenes, hydride
reductions,
the
Birch reduction, hydroboration,
and so on.
Surprisingly,
an
introduc-
tion
to the
manipulations
of
these reaction techniques
for the
undergraduate
or
grad-
uate student
has
failed
to
materialize,
and it is
often
necessary
for
students interested
in
organic synthesis
to
approach
modern synthetic reactions
in a
haphazard manner.
The
purpose
of
this text
is to
provide
a
survey,
and
systematic introduction
to, the
modern techniques
of
organic synthesis
for the
advanced undergraduate student
or the
beginning
graduate student.
An
attempt
has
been made
to
acquaint
the
student with
a
variety
of
laboratory techniques
as
well
as to
introduce
him to
chemical reagents
that
require
deftness
and
care
in
handling. Experiments have been drawn
from
the
standard
literature
of
organic synthesis including suitable modifications
of
several
of the
reliable
and
useful
preparations
that
have appeared
in
"Organic
Synthesis."
Other examples
have been drawn
from
the
original literature. Where ever possible,
the
experiments have
been adapted
to the
locker complement commonly
found
in the
advanced synthesis
course employing intermediate scale standard taper glassware. Special equipment
for
the
performance
of
some
of the
syntheses would include low-pressure hydrogenation
apparatus,
ultraviolet lamps
and
reaction vessels,
Dry Ice
(cold
finger)
condensers,
vacuum
sublimation
and
distillation apparatus,
and
spectroscopic
and
chromato-
graphic
instruments.
In
general,
an
attempt
has
been made
to
employ
as
substrates
materials that
are
available commercially
at
reasonable
cost,
although several
of the
experiments
require precursor materials whose preparation
is
detailed
in the
text. Some
of
the
reagents
are
hazardous
to
handle,
but I
believe that, under reasonable supervision,
advanced students
will
be
able
to
perform
the
experiments with
safety.
Introductory
discussion
of the
scope
and
mechanism
of
each reaction
has
been kept
to a
minimum.
Many excellent texts
and
reviews
exist that provide thorough
and ac-
curate
discussion
of the
more theoretical aspects
of
organic synthesis,
and
the
student
is
referred
to
these sources
and to the
original literature
frequently.
Since
it is the
purpose
XIl
PREFACE
of
this volume
to
provide technical procedures,
no
useful
purpose would
be
served
in
merely
duplicating previously explicated theoretical material.
The
number
of
experiments that
can be
done satisfactorily
in a
one-semester course
varies
widely
with
the
physical situation
and the
individual
skills
of the
student.
Therefore,
no
attempt
is
made
to
suggest
a
schedule.
I
recommend, however, that
a
common core
of
about
five
experiments
be
assigned.
The
remainder
of the
preparations
can
then
be
chosen
by
individual students
as
dictated
by
their interests
as
well
as by the
availability
of
chemicals
and
special equipment.
The
common experiments, representing
frequently
used
and
important techniques, might
be
chosen
from
Chapter
1,
Sections
I
and
IV;
Chapter
2,
Section
I;
Chapter
3,
Section
I;
Chapter
4,
Section
I;
Chapter
5,
Section
I;
Chapter
6,
Sections
III and IV;
Chapter
7,
Sections
II and
VI;
Chapter
8,
Section
II;
Chapter
9,
Sections
I and
II;
Chapter
11,
Sections
I and
III;
or
Chapter
13,
Section
II.
Since many
of the
other experiments draw
on the
products
of
this suggested
list,
the
possibility
of
multistep syntheses also presents itself,
and
several such sequences
are
outlined
in
Appendix
1.
Also included,
in
Appendix
2, are the
commercial suppliers
of
the
chemicals required when these chemicals
are not
routinely available.
Finally,
a
brief introduction
to the
techniques
of
synthesis
is
given
in
Appendix
3.
Students
with
no
synthetic experience beyond
the first-year
organic chemistry course
are
advised
to
skim through this section
in
order
to
acquaint themselves with some
of
the
apparatus
and
terminology used
in the
description
of
synthetic procedures.
RICHARD
S.
MONSON
I
FUNCTIONAL
GROUP
MODIFICATIONS
1
Chemical
Oxidations
The
controlled oxidation
of
selected functional groups
or
specific
skeletal positions
represents
one of the
most important aspects
of
synthetic organic chemistry.
The
application
of a
variety
of
inorganic oxidizing agents
to
organic substrates
has
broadened
considerably
the
selectivity with which such oxidations
may be
carried out.
The
examples
given
here
are
typical
of
this rapidly expanding area
of
functional group modification.
I.
Chromium Trioxide Oxidation
A
variety
of
chromium (VI) oxidizing systems have been developed which allow
for
the
oxidation
of a
wide range
of
sensitive compounds.
One of the
most widely used
chromium (VI) reagents
is the
Jones reagent (7), whose
use is
detailed
in the
procedure.
A
related system employs acetic acid
as the
solvent,
and an
example
of
this reagent
is
also given.
A
recently discovered
(2)
oxidizing system promises
to
become very important
for
the
oxidation
of
acid-sensitive compounds.
The
reagent
is
chromium trioxide-pyridine
complex, which
may be
isolated
after
preparation
and
employed
in
nonaqueous
solvents
(usually
methylene
chloride).
A
remarkable feature
of the
reagent
is
that
good
yields
of
aldehydes
are
obtained
by
direct oxidation
of
primary alcohols.
The
pre-
paration
of the
reagent
and its use are
given.
A.
OXIDATION
OF A
COMMERCIAL MIXTURE
OF
cis-
AND
trans-4-t-BuiYLCYCLOHEXANOL
H
2
Cr
2
O
7
The
chromic acid
oxidizing
reagent
is
prepared
by
dissolving 13.4
g of
chromium
trioxide
in 25 ml of
water.
To
this solution
is
added
12
ml of
concentrated
sulfuric
acid.
An
additional minimum quantity
of
water
is
added
if
necessary
to
dissolve
any
precipitated salts.
A
solution
of
15.6
g
(0.1
mole)
of
4-t-butylcyclohexanol
in 250 ml of
acetone
is
placed
in a
500-ml
three-necked
flask fitted
with
a
dropping
funnel,
a
thermometer,
and
4 1.
CHEMICAL OXIDATIONS
a
mechanical stirrer.
The
stirred solution
is
cooled
in a
water bath
to
20°,
and the
chromic acid oxidizing solution
is
added
from
the
dropping
funnel
slowly,
so
that
the
temperature
of the
reaction mixture does
not
exceed
35°.
The
addition
is
continued
until
the
orange color
of the
reagent persists
for
about
20
minutes.
The
excess oxidizing
agent
is
destroyed
by the
addition
of a
small quantity
of
isopropyl alcohol
(1 ml is
usually
sufficient).
The
mixture
is
decanted into
an
Erlenmeyer
flask, the
residual green salts
are
washed
with
two
15-ml
portions
of
acetone,
and the
washings
are
added
to the
main acetone
solution. Cautiously, sodium bicarbonate (approx.
13
g) is
added
to the
solution with
swirling
until
the pH of the
reaction mixture
is
neutral.
The
suspension
is filtered, and
the
residue
is
washed with
10-15
ml of
acetone.
The filtrate is
transferred
to a
round-
bottom
flask and
concentrated
on a
rotary evaporator under
an
aspirator while
the
flask
temperature
is
maintained
at
about
50°.
The flask is
cooled
and the
residue
transferred
to a
separatory
funnel.
(If
solidification
occurs,
the
residue
may be
dissolved
in
ether
to
effect
the
transfer.)
To the
funnel
is
added
1OO
ml of
saturated sodium chloride
solution,
and the
mixture
is
extracted with
two
50-ml
portions
of
ether.
The
ether
extracts
are
combined, washed with several
5-ml
portions
of
water, dried over anhydrous
magnesium
sulfate,
and filtered
into
a
round-bottom
flask. The
ether
may be
distilled
away
at
atmospheric pressure (steam
bath)
or
evaporated
on a
rotary
evaporator.
On
cooling,
the
residue should crystallize.
If it
does
not,
it may be
treated with
5 ml of
30-60°
petroleum ether,
and
crystallization
may be
induced
by
cooling
and
scratching.
The
crystalline product
is
collected
by filtration and
recrystallized from aqueous
methanol.
4-t-Butylcyclohexanone
has
mp
48-49°
(yield
60-90%).
B.
4-BENZOYLOXYCYCLOHEXANONE
FROM
THE
ALCOHOL
(3)
c
6
H
5
cooV^Y-°
H
T^T-
c
6
H
5
coo^
The
oxidizing agent
is
prepared
by
dissolving
9.7 g
(0.097 mole, 0.146 equivalents)
of
chromium
trioxide
in a
mixture
of 6 ml of
water
and 23 ml of
acetic acid.
A
250-ml
three-necked
flask is
equipped with
a
dropping
funnel,
a
thermometer,
and a
mechanical stirrer,
and is
charged with
a
solution
of 22 g
(0.10
mole)
of
4-benzoyl-
oxycyclohexanol
(Chapter
7,
Section
X) in 40 ml of
acetic acid.
The
solution
is
cooled
in
a
water
bath,
and the
oxidizing solution
is
added
at a
rate
so as to
maintain
the
reaction temperature below 35°.
After
completion
of the
addition,
the
reaction mixture
is
allowed
to
stand
at
room temperature overnight.
The
mixture
is
extracted with
150
ml
of
ether,
and the
ethereal solution
is
washed four times with
100-ml
portions
of
water
to
remove
the
bulk
of the
acetic acid.
The
ethereal solution
is
then washed with sodium
bicarbonate solution followed
by
water
and
then dried over sodium sulfate.
The
ether
is
evaporated,
and the
residue
solidifies.
The
product keto ester
may be
recrystallized
from
ether-petroleum
ether giving plates,
mp
62-63°.
The
yield
is
about
18
g
(82%).
II.
PERIODATE-PERMANGANATE CLEAVAGE
OF
OLEFINS
5
C.
CHROMIUM TRIOXIDE-PYRIDINE COMPLEX
(2, 4)
CrO
3
+ 2
C
5
H
5
N
->
CrO
3
(C
5
H
5
N)
2
Caution:
The
order
of
addition
must
be
observed
in
this procedure
or
inflammation
may
occur.
A
1
-liter
flask is
equipped with
a
magnetic stirrer,
a
thermometer immersed
in the
reaction mixture,
and a
drying tube.
In the flask is
placed
100 ml of
anhydrous pyridine,
and the flask is
cooled
in an
ice-
water
bath
to
15-20°
(lower temperatures impede
the
complex formation). Chromium trioxide
(80 g) is
added
in
small portions
to the
stirred
solvent
at a
rate
so as to
keep
the
temperature below 30°.
After
about one-third
of the
chromium
trioxide
has
been added,
the
yellow complex begins
to
precipitate.
At the
end of the
addition (about
1
hour),
a
slurry
of the
yellow complex
in
pyridine remains.
(This form
of the
complex
is
apparently
a
microcrystalline form
and is
very
difficult
to
handle.)
The
temperature
of the
stirred solution
is
readjusted
to
15°,
and
stirring
at
this
temperature
is
continued until
the
precipitate reverts
to a
deep
red
macrocrystalline
form.
Petroleum ether (200
ml) is
then added
to the
reaction mixture,
the
precipitate
is
allowed
to
settle,
and the
solvent mixture
is
decanted.
The
residue
is
washed three
times with
200-ml
portions
of
30-60°
petroleum ether,
the
solvent being removed each
time
by
decantation.
The
precipitate
is
collected
by
suction
filtration,
dried
at
room
temperature under
a
vacuum
of 10 mm
(higher vacuum causes some surface decom-
position),
and
stored
in a
desiccator. (The complex readily forms
a
hydrate, which
is
not
soluble
in
organic solvents. Consequently, protection
from
moisture
is
necessary.)
D.
OXIDATION WITH CHROMIUM
TRIOXIDE-PYRIDINE
COMPLEX:
GENERAL PROCEDURE
R_
CH
-R(H)
R
_
C
_
R(H)
OH
O
A 5 %
solution
of
chromium trioxide-pyridine complex
in dry
methylene
chloride
is
prepared.
The
alcohol (0.01 mole)
is
dissolved
in dry
methylene chloride
and is
added
in
one
portion
to the
magnetically stirred oxidizing solution
(310
ml,
a
6:
1
mole ratio)
at
room temperature.
The
oxidation
is
complete
in
5-15
minutes
as
indicated
by the
precipitation
of the
brownish black chromium reduction products.
The
mixture
is
filtered and the
solvent
is
removed (rotary evaporator) leaving
the
crude product,
which
may be
purified
by
distillation
or
recrystallization. Examples
are
given
in
Table 1.1.
II.
Periodate-Permanganate
Cleavage
of
Olefins
Oxidative
cleavage
of
olefins
is
frequently
a
useful
procedure synthetically
as
well
as
analytically.
Ozonization
is an
effective
means
of
carrying
out
such
a
cleavage under
1.
CHEMICAL
OXIDATIONS
TABLE
1.1
Alcohol
2-Butanol
2-Octanol
Cyclohexanol
Benzhydrol
1-Heptanol
Benzyl
alcohol
4-Nitrobenzyl
alcohol
3-Hydroxybenzyl
alcohol
Product
2-Butanone
2-Octanone
Cyclohexanone
Benzophenone
Heptanal
Benzaldehyde
4-Nitrobenazldehyde
3-Hydroxybenzaldehyde
bp(mp)/l
atm
of
product
(
0
Q
80
173
156
(50-52)
155
179
(105-106)
(101-103)
(%)
Yield
98
97
98
96
93
95
97
87
mild
conditions
but is not
always convenient.
The
procedure given here, discovered
by
Lemieux (5), employs
a
mixture
of
permanganate
and
periodate.
The
permanganate
oxidizes
the
olefin
to the
1,2-diol
and the
periodate cleaves
the
diol.
The
products
are
ketones
or
carboxylic acids, since
any
aldehydes produced
are
readily oxidized
in the
reaction medium.
The
troublesome accumulation
of
manganese dioxide
is
avoided
in
this reaction because
any
lower-valent
derivatives
of
manganese that
are
formed
are
reoxidized
to
permanganate
ion by the
periodate.
A
good example
of the use of the
reaction
is
shown (6).
The
experimental procedure
for the
cleavage
of
commercial
MnO
4
©
CH
2
OH
5-10°
CH
2
OH
OH
+
CH
1
COCH,
camphene
is
typical.
CAMPHENILONE FROM
CAMPHENE
,CH
2
KMnO
4
NaIO
4
O
CH
2
O
A
1-liter
three-necked
flask
equipped with
a
mechanical stirrer
and two
dropping
funnels
is
charged with
a
solution
of 42 g
(0.176
mole)
of
sodium periodate
in 145 ml of
acetone
and
180
ml of
water.
To the
stirred solution, camphene (6.7
g,
0.049
mole)
is
added
in
small portions.
The
reaction vessel
is
then
flushed
with
nitrogen
and is
main-
III.
FREE
RADICAL
OXIDATION
OF AN
ALLYLIC
POSITION
7
tained under
a
nitrogen atmosphere thereafter.
The
stirred solution
is
cooled
in an ice
bath
to 5°, and a
solution
of
potassium permanganate (1.3
g,
0.008
mole)
in 50 ml of
water
is
added dropwise with
the
simultaneous dropwise addition
of 50 ml of
acetone
over
1
hour,
the
temperature being held
at
5-10°.
After completion
of the
addition,
the
stirring
is
continued
for
12
hours
at
5-10°.
The
stirring
is
then discontinued,
the
reaction
mixture
is
allowed
to
settle
briefly,
and the
liquid reaction medium
is
decanted from
the
residue
(or filtered
through celite,
if
desired).
The
solution
is
placed
on a
rotary
evaporator,
and
acetone
is
removed under reduced pressure.
The
residual aqueous
phase
is
extracted three times with
50-ml
portions
of
ether;
the
ether
is
washed once
with
saturated sodium chloride solution
and
dried. Removal
of the
ether affords
the
crude ketone
in
almost quantitative yield.
It may be
purified
by
distillation,
bp
68-69°/!
5
mm,
193-194°/l
atm.
DL-Camphenilone
may be
recrystallized from aqueous
ethanol,
mp
40°.
III.
Free
Radical Oxidation
of an
Allylic
Position
The
allylic position
of
olefins
is
subject
to
attack
by
free
radicals with
the
consequent
formation
of
stable
allylic
free radicals. This fact
is
utilized
in
many substitution
reactions
at the
allylic position (cf.
Chapter
6,
Section III).
The
procedure given here
employs
t-butyl
perbenzoate, which reacts with cuprous
ion to
liberate
t-butoxy
radical,
the
chain reaction initiator.
The
outcome
of the
reaction, which
has
general
applica-
bility,
is the
introduction
of a
benzoyloxy group
in the
allylic position.
3-BENZOYLOXYCYCLOHEXENE
FROM CYCLOHEXENE
(7)
OCOC
6
H
5
C
6
H
5
COOC(CH
3
)
3
+
(CH
3
)
3
COH
O
Caution:
The
reaction
and the
subsequent solvent removal
and
product distillation steps
must
be
carried
out
behind
a
safety
screen.
A
250-ml,
three-necked, round-bottom
flask is
equipped with
a
mechanical stirrer,
a
reflux
condenser,
a
pressure-equalizing dropping
funnel,
and a
nitrogen inlet
and
outlet (mercury
filled
U-tube).
The flask is
charged
with
a
mixture
of 41 g
(0.50 mole)
of
cyclohexene
and
0.05
g of
cuprous bromide,
and the
mixture
is
heated (oil bath
or
mantle)
to
80-82°.
When
the
temperature stabilizes,
stirring
is
begun
and 40 g
(0.2
1
mole)
of
t-butyl perbenzoate
is
added dropwise over
a
period
of
about
1
hour. Stirring
and
heating
are
continued
for an
additional
3|
hours.
The
reaction mixture
is
cooled
and
washed twice
with
50-ml portions
of
aqueous sodium carbonate
to
remove benzoic
8
1.
CHEMICAL
OXIDATIONS
acid.
The
organic
phase
is
washed with water until neutral
and
dried over anhydrous
sodium sulfate. Excess
cyclohexene
is
removed
by
distillation under
aspirator
pressure,
and the
residue*
is
distilled through
a
short
column giving
20-33
g
(71-80%)
of
3-benzoyloxycyclohexene,
bp
97-99°/0.15
mm,
n™
1.5376-1.5387.
IV.
Epoxidation
of
OIefins
The
reactions
of
olefins
with peracids
to
form epoxides allows
for the
selective
oxidation
of
carbon-carbon
double bonds
in the
presence
of
other functional
groups
which
may be
subject
to
oxidation (for example, hydroxyl groups).
The
epoxides
that
result
are
easily cleaved
by
strong acids
to
diols
or
half-esters
of
diols
and are
therefore
useful
intermediates
in the
synthesis
of
polyfunctional compounds.
Caution:
All
reactions with organic peroxides should
be
conducted behind
a
safety
shield,
since peroxides occasionally explode.
A.
PERBENZOIC
ACID
EPOXIDATION
OF
STYRENE
(S)
C
6
H
5
CH=CH
2
+
C
6
H
5
C-OOH
>
C
6
H
5
CH-CH
2
+
C
6
H
5
COOH
''
r\
O
°
A
solution
of 21 g
(0.15
mole)
of
perbenzoic acid
(Chapter
17,
Section
II) in 250 ml
of
chloroform
is
prepared
in a
500-ml
round-bottom
flask.
Styrene
(15
g,
0.145
mole)
is
added,
and the
solution
is
maintained
at 0° for 24
hours
with
frequent shaking during
the first
hour.
At the end of the
reaction period, only
the
slight excess
of
perbenzoic
acid remains.
The
benzoic acid
is
extracted
from
the
reaction mixture
by
washing
several times with
10%
sodium hydroxide solution.
The
solution
is
then washed with
water
and
dried over anhydrous sodium
sulfate.
Fractional distillation gives
24-26
g
(69-75%)
of
1,2-epoxyethylbenzene,
bp
101°/40
mm.
B.
MONOPERPHTHALIC
ACID
EPOXIDATION
OF
CHOLESTERYL ACETATE
(8)
AcO
*
Since
the
perester
may
decompose
explosively
on
excessive heating,
an
infrared
spectrum
of the
residue
should
be run
prior
to
distillation
to
check
for
complete
reaction.
For
/-butyl
perbenzoate,
i>c=ois
1775cm-
1
(5.63/x).
V.
BAEYER-VILLIGER OXIDATION
OF
KETONES
9
A
solution
of 10 g
(0.023 mole)
of
cholesteryl
acetate
(mp
112-114°)
in
ether
(50 ml)
is
mixed with
a
solution containing
8.4 g
(0.046
mole)
of
monoperphthalic acid (Chapter
17,
Section
II) in 250 ml of
ether.
The
solution
is
maintained
at
reflux
for 6
hours,
following
which
the
solvent
is
removed
by
distillation (steam bath).
The
residue
is
dried
under vacuum
and
digested with
250 ml of dry
chloroform. Filtration
of the
mixture
gives
6.7 g of
phthalic
acid
(87%
recovery).
The
solvent
is
evaporated from
the filtrate
under reduced pressure
and the
residue
is
crystallized from
30 ml of
methanol, giving
6.0 g (58 %
yield)
of
/?-cholesteryl
oxide acetate. Recrystallization
affords
the
pure
product,
mp
111-112°.
Concentration
of the filtrate
yields 1.55
g
(15% yield)
of
a-cholesteryl
oxide acetate which
has a mp of
101-103° after crystallization
from
ethanol.
C.
HYDROXYLATION
OF
CYCLOHEXENE WITH HYDROGEN PEROXIDE-FORMIC
ACID
(8,
9)
H
2
Q
2
HCOOH
>
Cyclohexene
(8 g,
0.097 mole)
is
added
to a
mixture
of 105 g of
98-100
%
formic acid
and 13 g
(0.115
mole)
of
30%
hydrogen peroxide contained
in a
250-ml
flask fitted
with
a
reflux
condenser.
The two
layers
are
shaken together
briefly,
whereupon spontaneous
heating occurs.
The
mixture becomes homogeneous
at
65-70°,
this temperature being
maintained
for 2
hours
on a
steam
bath.
The
formic acid
is
removed
by
distillation
under reduced pressure.
The
residue
is
mixed with
50 ml of 6
TV
sodium hydroxide
and
heated
on a
steam bath
for 45
minutes.
The
solution
is
cooled, neutralized with hydro-
chloric acid
and
evaporated
to
dryness under vacuum.
The
solid residue
is
distilled,
affording
about
10 g of the
product,
bp
128-132°/15
mm. The
distillate
solidifies
and
may be
recrystallized from acetone, giving about
70%
of
trans-
1,2-cyclohexanediol,
mp
102-103°.
V.
Baeyer-Villiger Oxidation
of
Ketones
The
reaction
of
peracids with ketones proceeds relatively slowly
but
allows
for the
conversion
of
ketones
to
esters
in
good yield.
In
particular,
the
conversion
of
cyclic
ketones
to
lactones
is
synthetically
useful
because only
a
single product
is to be
expected.
The
reaction
has
been carried
out
with both percarboxylic acids
and
Caro's
acid (formed
by the
combination
of
potassium persulfate
with
sulfuric
acid). Examples
of
both
procedures
are
given.
A.
PERBENZOIC ACID OXIDATION
OF
KETONES: GENERAL PROCEDURE
(10)
RCCH
3
-I-
C
6
H
5
COOH
^^^
R-OCCH
3
+
C
6
H
5
COOH
OO
O
10 1.
CHEMICAL
OXIDATIONS
A
perbenzoic acid solution
in
benzene
is
prepared
as in
Chapter
17,
Section
II.
(This solution
is
approximately
1.8 M in
perbenzoic acid.)
To 67 ml
(approx.
0.12
mole
of
perbenzoic acid)
of
this solution contained
in an
Erlenmeyer
flask is
added
0.10
mole
of
the
ketone
in one
batch.
The
resulting solution
is
swirled
at
intervals
and
allowed
to
stand
at
room temperature
for 10
days.
The
solution
is
then washed three times with
50-ml
portions
of
saturated sodium bicarbonate solution
to
remove benzoic acid
and
unreacted peracid,
and is
then washed with water.
The
solution
is
dried (anhydrous
sodium sulfate),
the
benzene
is
evaporated,
and the
residue
is
fractionally distilled
at
reduced pressure
to
give
the
ester.
Examples
1.
Cyclohexyl
methyl ketone gives cyclohexyl acetate,
bp
74-77°/23
mm.
2.
Cyclohexanone gives
e-caprolactone,
bp
102-104°/?
mm,
which
may
polymerize
on
standing.
The
lactone
may be
converted easily
to the
corresponding
e-hydroxy-
hydrazide
by
heating
on a
steam bath with
a
slight excess
of
100%
hydrazine hydrate.
The
crude
hydrazide
may be
recrystallized
from
ethyl
acetate,
mp
114-115°.
PERSULFATE OXIDATION
OF
KETONES:
GENERAL PROCEDURE
(7/)
K
2
S
2
O
8
R-C-CH
3
>
R-O-C-CH
3
Il
H
2
SO
4
Il
O
O
The
oxidizing agent
is
prepared
in a
500-ml
flask
equipped with
a
magnetic stirrer
and
cooled
in an ice
bath
as
follows:
In the flask are
placed
60 ml of
concentrated
sulfuric
acid
and 20 ml of
water,
and the
solution
is
cooled
to
10°. Potassium persulfate
(42 g,
0.15
mole)
is
added
slowly
to the
stirred solution while maintaining
the
temperature
below
10°.
The
solution
is
diluted with
an
additional
65 ml of
water maintaining
the
temperature below
15°.
The
solution
is now
cooled
to
about
7° and
0.08 mole
of the
ketone
is
added over
40
minutes.
After
the
addition
has
been completed,
the
solution
is
allowed
to
come
to
room temperature
and
stirring
is
continued
for 20
hours.
The
solution
is
diluted
carefully
with
150
ml of
water
and
extracted twice with
75-ml
portions
of
ether.
The
ether
is
washed with sodium bicarbonate solution, followed
by
water,
and
the
ethereal solution
is
dried. Removal
of the
solvent, followed
by
fractional distillation,
affords
the
product ester.
Examples
1.
Cyclopentanone gives
S-valerolactone,
bp
98-100°/5
mm. The
lactone
may be
converted
as
above
to its
8-hydroxyhydrazide
and
recrystallized
from
ethyl acetate,
mp
105-106°.
2.
2-Methylcyclopentanone
gives
S-methyl-S-valerolactone,
bp
100-101
°/5 mm.
VIL
CYCLOHEXANE
TO
CYCLOHEXANONE OXIME
11
VI.
Lead
Tetraacetate
Oxidation
of
Cycloalkanols
The
reaction
of
lead tetraacetate (LTA) with monohydric alcohols produces
functionalization
at a
remote site yielding derivatives
of
tetrahydrofuran (THF) (12).
An
example
is the
reaction
of
1-pentanol
with
LTA in
nonpolar solvents which produces
30%
THF.
The
reaction, which
is
believed
to
proceed through free-radical inter-
mediates, gives
a
variable distribution
of
oxidation products depending
on
solvent
polarity, temperature, reaction time, reagent ratios,
and
potential angle strain
in the
product.
In the
procedure given here,
the
reaction
is
applied
to a
cyclic alcohol
to
produce
a
bridged ether.
The
product
is of
interest
in
that
it can be
cleaved
to
produce disubstituted
cyclooctanes
of
known geometry (cf.
Chapter
6,
Section
V).
LEAD
TETRAACETATE
OXIDATION
OF
CYCLOOCTANOL
(13)
PH OAc
Pb(QAc)
4
benzene
A
mixture
of 200 ml dry
benzene, 35.5
g
(0.08 mole)
of
lead tetraacetate,
and 15 g of
anhydrous calcium carbonate
is
placed
in a
500-ml
round-bottom
flask
equipped with
a
magnetic stirrer,
a
heating mantle,
and a
condenser (drying tube).
The
mixture
is
heated with stirring
to
reflux.
Ten
grams (0.078 moles)
of
cyclooctanol dissolved
in 50
ml
of dry
benzene
are
added
in one
batch,
and the
mixture
is
refluxed
for 48
hours.
The
mixture
is
then cooled
and filtered by
suction through celite. Water
(25 ml) is
added
to
the
filtrate,
and the
solution
is
stirred
for
\
hour
to
hydrolize
any
unreacted lead tetra-
acetate.
The
mixture
is
then
filtered
again
by
suction through celite giving
a
clear
two-phase
filtrate. The
water layer
is
separated,
and the
benzene layer
is
dried over
anhydrous
sodium sulfate,
filtered, and
fractionally
distilled.
The
major product
is the
cyclic
oxide which
has bp
50-52°/6.5
mm and mp
30-32°.
VII.
Photolytic
Conversion
of
Cyclohexane
to
Cyclohexanone Oxime
Nitrosyl
chloride reacts with aliphatic hydrocarbons
at
room temperature under
the
influence
of
light
to
give
a
complex mixture
of
substitution products. When
the
reaction
is run on
cyclohexane
at
—25°,
however,
the
pure
oxime
hydrochloride
crystallizes
from
the
reaction mixture with
virtually
no
side products.
12 1.
CHEMICAL
OXIDATIONS
A.
CYCLOHEXANONE OXIME FROM CYCLOHEXANE
(14)
,
_
NOH-HCl
+
NOCl
—
Caution:
Nit
rosy
I
chloride
is an
extremely corrosive
gas,
and all
operations with
it
should
be
carried
out in a
hood.
A
500-ml
three-necked
flask is fitted
with
a gas
inlet tube,
a
magnetic stirrer,
and an
alcohol thermometer,
and is
immersed
in a Dry
Ice-acetone
bath
to a
depth
sufficient
to
maintain
an
internal temperature
of
—20
to
—25°.
Four
150-watt
spotlights
are
mounted around
the flask. The
cooling bath
and the gas
inlet tube should
be
protected
from
the
light
by
covering with aluminum
foil.
A
cyclohexane-benzene mixture
(70:30
by
volume)
is
placed
in the flask to a
convenient volume
(100-200
ml) and is
allowed
to
cool
to
—20°.
The
lamps
are
turned
on, and
nitrosyl chloride
is
added slowly
to the flask
through
the
immersed
gas
inlet tube.
The
solution gets cloudy
in
about
10
minutes
and
cyclohexanone
oxime
hydrochloride
precipitates
in
15-20 minutes.
The
addition
of a
total
of 7 g of
nitrosyl chloride should take about
5
hours. Under these
circumstances about
9 g of the
oxime hydrochloride
can be
isolated
by filtration
followed
by
washing with ether
and
drying
in a
vacuum oven
or
desiccator.
The
oxime
hydrochloride
has
mp
70-88°
and is
quite hygroscopic.
It may be
converted
to the
free
oxime
by the
following procedure:
The
oxime hydrochloride
(8 g) is
suspended
in
180
ml of
boiling
dry
ether.
Dry
ammonia
is
bubbled slowly through
the
mixture
for
several hours.
The
ammonium chloride formed
is filtered
off,
and the
ether
is
removed
from
the filtrate on a
rotary evaporator. This residue
is
recrystallized from petroleum
ether.
The
free
oxime
has mp
88-90°.
Vm.
Oxidation
of
Ethers
to
Esters
The
oxidation
of
ethers
to
esters according
to the
reaction
offers
many possibilities
for
the
modification
of
functionality
in
open chain
or
cyclic systems.
An
example
is the
R-CH
2
-O-R'
>
R—C—O—R'
O
conversion
of
tetrahydrofurans
to
y-butyrolactones.
Two
reagents have been dis-
covered that allow
for
this conversion
in
satisfactory
yield:
ruthenium tetroxide
and
trichloroisocyanuric
acid (Chapter
17,
Section IV).
The use of
these reagents
is
given
below
for the
conversion
of
di-n-butyl
ether
to
n-butyl
n-butyrate.
A.
n-BuiYL
BUTYRATE FROM
DI-W-BUTYL
ETHER
BY
RUTHENIUM TETROXIDE
(CH
3
CH
2
CH
2
CH
2
)
2
O
R
"°
4
>
CH
3
CH
2
CH
2
COCH
2
CH
2
CH
2
CH
3
O
IX.
PARTIAL OXIDATION
OF AN
ALIPHATIC
SIDE
CHAIN
13
1.
Preparation
of
Ruthenium Tetroxide
(15):
In a
250-ml
flask
equipped with
a
magnetic
stirrer
and
cooled
in an
ice-salt
bath
is
placed
a
mixture
of 0.4 g of
ruthenium dioxide
and 50 ml of
carbon
tetrachloride.
A
solution
of 3.2 g of
sodium metaperiodate
in 50
ml
of
water
is
added
and the
mixture
is
stirred
1
hour
at 0°. The
black ruthenium dioxide
gradually dissolves.
The
clear yellow carbon tetrachloride layer
is
separated
and
filtered
through
glass wool
to
remove insoluble materials.
The
solution
may be
used
immediately
or
stored
in the
cold
in the
presence
of 50 ml of
sodium metaperiodate
solution
(1
g/50 ml).
As
prepared above,
the
solution
is
about 0.037
M in
ruthenium
tetroxide
and
contains
0.3
g/50
ml.
2.
Oxidation
of
Di-n-butyl
Ether (16):
The
ruthenium tetroxide solution (containing
about
0.3 g of the
oxidizing agent)
is
added dropwise
to a
magnetically stirred solution
of
0.40
g of
di-n-butyl
ether
in 10 ml of
carbon tetrachloride cooled
in an ice
bath.
A
thermometer
is
inserted
in the
reaction mixture. After
a few
minutes, black ruthenium
dioxide begins
to
form,
and the
temperature rises.
The
rate
of
addition
is
controlled
to
maintain
the
temperature
at
10-15°.
After
completion
of the
addition,
the
reaction
mixture
is
allowed
to
stand
at
room temperature overnight.
The
precipitated ruthenium
dioxide
is filtered
off,
and the
residue
is
washed thoroughly with carbon tetrachloride.
The
combined
filtrate and
washings
are
washed once with sodium bicarbonate solution
to
remove
a
trace
of
butyric acid.
The
carbon tetrachloride solution
is
then dried
(anhydrous sodium sulfate),
filtered, and
distilled
in a
micro-apparatus.
n-Butyl
n-butyrate
has a
normal boiling
point
of
165-166°.
B.
n-BuTYL
BUTYRATE FROM
DI-W-BUTYL
ETHER
BY
TRICHLOROISOCYANURIC
ACID
(17)
In a
200-ml
round-bottom
flask
equipped with
a
magnetic stirrer
and a
thermometer
is
placed
a
mixture
of 50 ml of
di-n-butyl ether
and 25 ml of
water.
The flask is
immersed
in
an ice
bath
and the
mixture
is
cooled
to 5°. In one
portion
is
added 23.2
g
(0.1
moles)
of
trichloroisocyanuric acid (Chapter
17,
Section IV),
and
stirring
in the ice
bath
is
continued
for 12
hours.
The ice
bath
is
removed
and the
mixture
is
stirred
at
room
temperature
for an
additional
8
hours.
The
reaction mixture
is
then
filtered to
remove
solids.
The
water
is
separated from
the
organic layer, which
is
then washed with
two
additional portions
of
water, dried with anhydrous sodium sulfate,
filtered, and
fractionated
as
above.
IX.
Partial
Oxidation
of an
Aliphatic Side Chain
As
mentioned earlier, allylic positions
are
highly subject
to
attack
by
free
radicals.
Likewise,
benzylic positions
may be
attacked
by
free-radical initiating reagents
to
give
benzylic
radicals
of
high stability.
The
procedure given below employs cerium (IV)
in
conjunction
with nitric acid
to
carry
out the
oxidation
of the
benzylic position
of
Tetralin. Although cerium (IV) reagents have been
widely
used
in
inorganic analytic
procedures, their
use in
organic oxidations
is
relatively recent.
14
1.
CHEMICAL
OXIDATIONS
a-TETRALONE
FROM TETRALIN (18)
A
three-necked round-bottom
flask is fitted
with
a
dropping
funnel,
a
thermometer,
and a
magnetic stirrer
and is
heated
in a
water bath
to
30°. Tetralin (1.32
g,
0.01 mole)
and 50 ml
of
3.5 N
nitric acid solution
are
placed
in the flask and
brought
to
temperature.
Cede
ammonium nitrate
(21.9
g,
0.04 mole)
is
dissolved
in 100 ml of 3.5
N
nitric
acid,
and the
solution
is
added dropwise
to the
reaction mixture
at a
rate
such
that
the
temperature does
not
rise
and
only
a
pale yellow color
is
evident
in the
reaction mixture.
At the
completion
of the
reaction
(I^
to 2
hours),
the
mixture should
be
colorless.
The
solution
is
cooled
to
room temperature, diluted
with
an
equal volume
of
water,
and
extracted twice
with
ether.
The
ether solution
is
dried
with
anhydrous sodium sulfate,
filtered, and the
ether
is
evaporated.
The
residue
may be
distilled
to
yield
a-tetralone
(bp
113-116°/6
mm or
170°/49
mm) or may be
converted directly
to the
oxime, which
is
recrystallized
from methanol,
mp
88-89°.
X.
Bisdecarboxylation with Lead
Tetraacetate
The use of
lead
tetraacetate
to
carry
out
oxidative bisdecarboxylation
of
diacids
has
been found
to be a
highly
useful
procedure when used
in
conjunction with
the
Diels-
Alder
addition
of
maleic anhydride
to
dienes,
the
latter process providing
a
ready
source
of
1,2-dicarboxylic
acids.
The
general pattern
is
illustrated
in the
reaction
COOH
COOH
LTA
sequence.
A
striking
use of the
reaction
was
made
by van
Tamelen
and
Pappas
(19)
in
their synthesis
of
Dewar benzene.
LTA
XI.
OXIDATION WITH SELENIUM DIOXIDE
15
General
Procedure (20)
rnnH
LTA
pyridine
Pyridine
(purified
by
distillation
from
barium oxide,
10
ml/g
of
diacid)
is
placed
in a
round-bottom
flask fitted
with
a
magnetic stirrer, condenser,
and
drying tube. Oxygen
is
bubbled
through
the
stirred solution
at
room temperature
for 15
minutes.
The
diacid
(0.02 mole)
and
lead tetraacetate (0.03 mole)
are
added,
and the flask is
heated with
a
mantle
or oil
bath
to 65°
while
the
stirring
is
continued.
The
evolution
of
carbon dioxide
begins
after
several minutes
and is
usually complete after
an
additional
10
minutes.
The
reaction mixture
is
cooled,
poured into excess dilute nitric acid,
and
extracted with
ether.
The
ether solution
is
washed with aqueous bicarbonate then
saturated
sodium
chloride solution
and finally
dried over anhydrous magnesium sulfate.
The
solution
is
filtered,
and
the
solvent
is
removed
by a
rotary
evaporator
or by
fractionation
to
give
the
olefin.
Examples
(20)
1.
c/s-4,5-Cyclohexenedicarboxylic
acid
(Chapter
8,
Section
II) is
converted
to
1,4-cyclohexadiene,
bp
86-87°,
n£°
1.4729.
2.
endo-l-Acetoxy-8,8-dimethylbicyclo[2.2.2]oct-3-one-5,6-dicarboxylic
acid gives
the
corresponding
olefin,
l-acetoxy-8,8-dimethylbicyclo[2.2.2]oct-2-ene-5-one,
mp
59-60°
after
recrystallization
from
pentane (Chapter
8,
Section IV).
3.
end0-l-Acetoxybicyclo[2.2.2]oct-3-one-5,6-dicarboxylic
acid gives
the
corre-
sponding
olefin,
l-acetoxybicyclo[2.2.2]oct-2-en-5-one,
mp
49-50°
after recrystal-
lization
from
pentane (Chapter
8,
Section IV).
XI.
Oxidation
with
Selenium Dioxide
Selenium
dioxide
may be
used
for the
oxidation
of
reactive
methylene
groups
to
carbonyl
groups.
An
example
is the
oxidation
of
cyclohexanone
to
cyclohexane-1,2-
dione
(27).
In the
procedure,
the
reaction
is
carried
out on
camphor
to
give
camphor
quinone,
an
intermediate
in the
preparation
of
Homer's
Acid (see Chapter
15,
Section
II).
16 1.
CHEMICAL OXIDATIONS
CAMPHOR QUINONE
(22)
SeO
2
Caution: Selenium dioxide
is
extremely poisonous
and
proper
care should
be
taken
when
working
with
it.
Commercial selenium dioxide gives more consistent results when
freshly
sublimed
material
is
used. Place
the
oxide
(50 g) in a
7-cm porcelain crucible upon which
is set a
250-ml
filter flask
cooled
by
running through
it a
stream
of
water.
The
crucible
is
heated
with
a low flame
until sublimation
is
complete
(20-30
minutes). After cooling,
the
sublimed selenium dioxide
is
scraped
from
the flask and is
stored
in a
stoppered bottle.
In a
100-ml
flask is
placed
a
mixture
of
19.5
g
(0.18 mole)
of
freshly
sublimed,
pulverized
selenium dioxide,
15 g
(O.
IO
mole)
of
^/-camphor
and
15
ml of
acetic anhy-
dride.
The flask is fitted
with
a
magnetic stirrer
and a
condenser,
and the
mixture
is
heated
to
135°
on an oil
bath with stirring
for 16
hours.
After
cooling,
the
mixture
is
diluted
with ether
to
precipitate selenium, which
is
then
filtered
off,
and the
volatile
materials
are
removed under reduced pressure.
The
residue
is
dissolved
in
ether (200 ml),
washed four times with
50-ml
portions
of
water
and
then washed several times
with
saturated sodium bicarbonate solution (until
the
washes
are
basic).
The
ether solution
is
finally
washed several times with water, then dried,
and the
ether
is
evaporated.
The
residue
may be
purified
by
sublimation
at
reduced pressure
or
recrystallized
from
aqueous
ethanol
(with clarification
by
Norit,
if
necessary).
The
product
is
yellow,
mp
197-199°.
REFERENCES
1.
A.
Bowers,
T. G.
Halsall,
E. R. H.
Jones,
and A. J.
Lemin,
/.
Chem.
Soc.,
p.
2548 (1953);
E. J.
Eisenbraun,
Org.
Syn.
45, 28
(1965);
K. B.
Wiberg,
ed., "Oxidation
in
Organic
Chemistry."
Academic
Press,
New
York, 1965.
2.
J. C.
Collins,
W. W.
Hess,
and F. J.
Frank,
Tetrahedron
Lett.,
p.
3363 (1968).
3.
E. R. H.
Jones
and F.
Sondheimer,
/.
Chem.
Soc.,
p. 615
(1949).
4.
G. I.
Poos,
G. E.
Arth,
R. E.
Beyler,
and L. H.
Sarett,
/.
Amer.
Chem. Soc.
75, 422
(1953);
J. R.
Holum,
J.
Org. Chem.
26,
4814 (1961).
5.
R. U.
Lemieux
and E. von
Rudloff,
Can.
J.
Chem.
33,
1701, 1710, 1714 (1955); Can.
J.
Chem.
34,
1413(1956).
6.
C. G.
Overberger
and H.
Kay,
/.
Amer.
Chem. Soc.
89,
5640
(1967).
7. K.
Pedersen,
P.
Jakobsen,
and S.
Lawesson,
Org. Syn.
48,
18
(1968)
and
references cited therein.
8.
D.
Swern, Org. React.
7, 378
(1953).
9. A.
Roebuck
and H.
Adkins, Org. Syn. Collective Vol.
4, 217
(1955).
10.
S. L.
Friess,
J.
Amer.
Chem. Soc.
71, 14,
2571 (1949).
11.
T. H.
Parliment,
M. W.
Parliment,
and I. S.
Fagerson,
Chem.
Ind.
(London),
p.
1845 (1966).
REFERENCES
17
12.
R. E.
Partch,
/.
Org.
Chem.
30,
2498
(1965);
K.
Heusler
and K.
Kalvoda,
Angew.
Chem.
Int.
Ed.
Engl.
3, 525
(1964).
13.
R. M.
Moriarty
and H. G.
Walsh,
Tetrahedron
Lett.,
p. 465
(1965).
14.
M. A.
Naylor
and A. W.
Anderson,
/.
Org. Chem.
18,
115
(1953).
15.
H.
Nakata,
Tetrahedron
19,
1959 (1963).
16.
L. M.
Berkowitz
and P. N.
Rylander,
/.
Amer.
Chem. Soc.
80,
6682 (1958).
17.
E. C.
Juenge
and D. A.
Beal,
Tetrahedron
Lett.,
p.
5819 (1968).
18.
L.
Syper,
Tetrahedron
Lett.,
p.
4493 (1966).
19.
E. E. van
Tamelen
and S. P.
Pappas,
/.
Amer. Chem. Soc.
85,
3297 (1963).
IQ.
C. M.
Cimarusti
and J.
Wolinsky,
/.
Amer.
Chem. Soc.
90,
113
(1968).
Zl.
C. C.
Hach,
C. V.
Banks,
and H.
Diehl,
Org. Syn. Collective Vol.
4,
229
(1963).
22.
R. R.
Pennelly
and J. C.
Shelton, private communication.